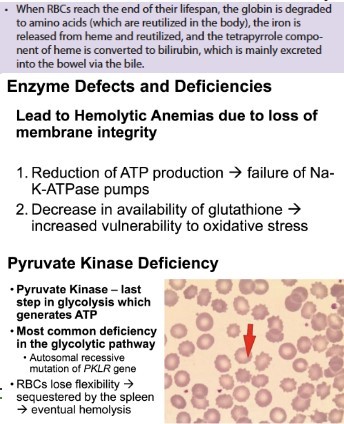

c. IgM
IgM antibodies are produced first, and tests for these are most effective when performed 7-10 days after exposure. IgM levels in the blood rise for a few weeks, then gradually decreases until they fall below detectable levels after a few months.
“IgM is the first immunoglobulin class produced in a primary response to an antigen. IgM antibodies are relatively short lived, and its half life in serum is 5 days.”
a. IL-1 and TNF-alpha
“Endotoxins produced by infectious bacteria stimulate macrophages to overproduce IL-1 and TNF-alpha that cause an often fatal form of bacterial septic shock.” Reference: Doc Bello’s Immunoglobulin and Complement System Handout 2020
b. fetus can synthesize IgM as early as this age of gestation
“IgM is the earliest immunoglobulin to be synthesized by the fetus beginning by about 20 weeks of age”. “The presence of IgM in the fetus or newborn indicates intrauterine infection and its detection is useful in the diagnosis of congenital infections such as Toxoplasmosis, syphilis, rubella, cytomegalovirus infection and HIV infection.” Reference: Doc Bello’s Immunoglobulin and Complement System Handout 2020. p. 37
a. F(abʼ)2 and pFc
Reference: Doc Bello’s Immunoglobulin and Complement System Handout 2020. p. 29

a. Hemoglobin histidine binding H+
“Our digestive juices contain a lot of bicarbonate to neutralize the gastric acid. When we have diarrhea, we can lose these and thus have acidosis (loss of bases). Our RBCs help correct this acid base imbalance through the histidine residues in the hemoglobin binding protons. The curve should shift to the right.” Reference: Doc Jan’s Hemoglobin and RBC Evaluation Rationale
a. Chronic obstructive lung disease
Erythropoiesis is driven by levels of hypoxia-inducible factors. Chronic obstructive lung disease would affect a patient’s ability to deliver oxygen to tissues, causing hypoxia. Polycythemia also refers to the increased number of RBCs in the body, and chronic lung diseases are a cause of secondary polycythemia. Reference: Doc Santos’s Hematopoiesis Ppt and Doc Monzon’s PPT Handout


b. occlusion of vessels
Priapism or the prolonged erection of the penis is characteristic of people suffering from hemolytic attacks due to sickle cell anemia. Vessels tend to get occluded due to the abnormal shape of RBCs and the lost ability to be pliable. The sickled cells obstruct venous blood flow which causes sustained erection of the penis. Reference: Doc Monzon’s PPT handout 2020. p. 63

d. IL1-Ra
Well-characterized cytokine antagonist is the naturally occurring IL-1 receptor antagonist (IL-1Ra). This protein also plays a role in regulating the intensity of inflammatory responses by binding to the IL-1 receptor on CD4+ T cells, thus preventing their activation. Binding of IL-1Ra to the IL-1 receptor does not mediate cell signaling through this receptor. IL-1Ra has been cloned and is currently under clinical investigation to determine whether it can be used as a therapeutic agent for chronic inflammatory diseases. Reference: “Immunoglobulin, Complement System, Cytokine 2020” notes given by Doc Bello
d. The immunoglobulin will clear the virus that enters the body.
“Passive immunity is provided when a person is given antibodies to a disease rather than producing them through his or her own immune system. A person can also get passive immunity through antibody-containing blood products such as immune globulin, which may be given when immediate protection from a specific disease is needed.” Reference: Vaccines and Immunization. https://www.cdc.gov/vaccines/vac-gen/immunity-types.htm
d. Enhancement of B cell response


d. iron deficiency anemia
Pigment gallstones are obstructions of the bile duct which can occur as a result of RBC breakdown associated with hemolytic anemia. It can be caused due to the loss of membrane integrity. Iron deficiency anemia is due to the inadequate intake or excessive loss of iron, which affects the oxygen-carrying capacity of the RBCs but does not affect the integrity of the membrane. Reference: Harper’s P. 648 and Doc Monzon’s PPT Handout
c. decay accelerating factor
Paroxysmal nocturnal hemoglobinuria is caused by an absence of decay acceleration factor which leads to uncontrollable complement activation. Decay acceleration factor (DAF) – a membrane protein that inhibits activation of the C3 complement component and thereby protects RBCs from uncontrollable complement activation. Reference: Doc Monzon’s Lecture
d. RH incompatibility
Hemolytic disease of the newborn happens during the second pregnancy of an RH- negative mother who has developed anti RH antibodies during her first pregnancy to an RH+ baby. RH incompatibility occurs when the anti-RH antibodies of the mother attack the RH+ 2nd born, causing intrauterine hemolytic anemia. Reference: Doc Monzon’s Lecture
b. Decreases affinity of hemoglobin to oxygen in tissues
2-3-BPG stabilizes the T(taut) structure of hemoglobin by making salt bridges that must be broken prior to conversion to the R state. T-state of hemoglobin allows more efficient unloading of oxygen molecules to the peripheral tissues as demand rises from increased cellular respiration due to working out. Reference: Doc Monzon’s Lecture

c. beta thalassemia
In people with beta thalassemia, low levels of hemoglobin lead to a lack of oxygen in many parts of the body. Affected individuals also have a shortage of red blood cells (anemia), which can cause pale skin, weakness, fatigue, and more serious complications. People with beta thalassemia are at an increased risk of developing abnormal blood clots. Beta thalassemia - Is a blood disorder that reduces the production of hemoglobin. Hemoglobin is the iron-containing protein in red blood cells that carries oxygen to cells throughout the body. Reference: Doc Monzon’s Ratio
a. Impaired mitochondrial
ATP production Cyanide Method of Toxicity - Cyanide’s main effect is that it inhibits oxidative phosphorylation, a process where oxygen is utilized for the production of essential cellular energy sources in the form of ATP. It does so by binding to the enzyme cytochrome C oxidase and blocks the mitochondrial transport chain. After that, cellular hypoxia and the depletion of ATP occur, leading to metabolic acidosis. The utilization of oxygen by the tissue occurs and is followed by the impairment of vital functions. Cyanide poisoning - may result from a variety of exposures including structural fires, industrial exposures, medical exposures such as sodium nitroprusside, and certain foods. Cyanide sometimes is described as having a “bitter almond” smell, but it does not always give off an odor, and not everyone can detect this odor Reference: Doc Monzon’s Ratio
b. Her Memory B cell recognized the antigen readily and transform itself into plasma cells to produce immunoglobulin against varicella
Memory B cells are non-proliferating, generally long-lived cells, that can be activated for a subsequent (secondary) and more rapid response to antigen. When reactivated, memory cells can be converted into plasma cells. They express isotypes other than IgM (IgG, IgA, or IgE) on their surface. IgG mediates against Varicella. Memory B cells – When secondary immune response is needed, memory B cells are activated against the pathogen and a rapid response to antigen is ensued. Reference: From Doc Bello’s prerequisite readings
d. It has a killer cell inhibitory receptor that recognizes MHC I of normal cells.
NK cells has receptors called Killer-Cell-Inhibitory-Receptors. These receptors bind to MHC class I molecules expressed in normal cells. When target cells are virus-infected cell and/or are tumor cells, they have significantly reduced to low number of MHC Class I molecules on their surfaces. The killer-cell-inhibitory-receptor of the NK cells will fail to engage the MHC1, leading to the infected cell becoming susceptible to NK cell mediated toxicity. Killer-cell-inhibitory-receptor – Binds to MHC Class I molecules in a normal cell to inhibit the toxic effects of NK cells. MHC Class I - Expressed virtually in all nucleated cells Reference: From Doc Bello’s prerequisite readings
b. Use natural barriers
Reference: From Doc Bello’s Immunoglobulin & Complement System ppt

a. Carbon monoxide poisoning
The pathology in Carbon monoxide poisoning is histotoxic anemia where the tissues, NOT RBCs (which do not have mitochondria), cannot utilize oxygen in the electron transport chain. Choices B-D are all hemolytic anemias because the RBC membranes are all vulnerable to oxidative stress or are poorly maintained due to lack of oxygen. In sickle cell anemia, the RBC shape is altered, also making RBCs easily lysed in small vessels. Reference: Doc Monzon’s Ratio
d. IgE
Functions: Activation of immediate hypersensitivity reaction (allergy) through basophil and mast cell degranulation Eosinophil activation (releasing the enzymes for defence against worm infection) Activation of antibody-dependent cell-mediated cytotoxicity (ADCC) involving eosinophils Reference: From Doc Bello’s prerequisite readings
BONUS The intended answer is C3bBb, but was incorrectly put as BbBb.
a. Plasmacytoid dendritic cell
Dendritic cell are critically important members of the innate immune system due to their high efficient APC properties that enable them to trigger adaptive immune responses carried out by T cell. Their ability to present antigens to T Cells far exceeds other antigen presenting cell PLASMACYTOID DENDRITIC CELL - type of dendtritic cell derived from lymphoid precursor cell. They also have antigen presenting skills and they also the ability to produce large amounts of alpha/beta interferons (IFN-A/B) in response to viral and bacterial stimuli. Type I interferons (IFN-α, IFN-β) are produced by plasmacytoid dendritic cells. Type I IFNs enhance the ability of NK cells to kill infected cells. In addition, part of the innate response to viral infections includes increased apoptosis of infected cells, which also helps to eliminate the reservoir of infection. Reference: Pre-requisite reading by Doc Bello in Immunology and Basic Immunology Function and Disorders of the Immune System, 5th Ed by A. Abbas
c. Virus will bind to the variable of heavy and light chains
Light Chain - smaller and lighter - L chain Heavy Chain - bigger and heavier - H chain Portion of Ig molecule that binds the specific antigen is formed by the amino/N terminal portions (variable) of both H & L chains Reference: Batch 2023 Ratio & Doc Bello’s Immunoglobulin and Complement System Handout 2020